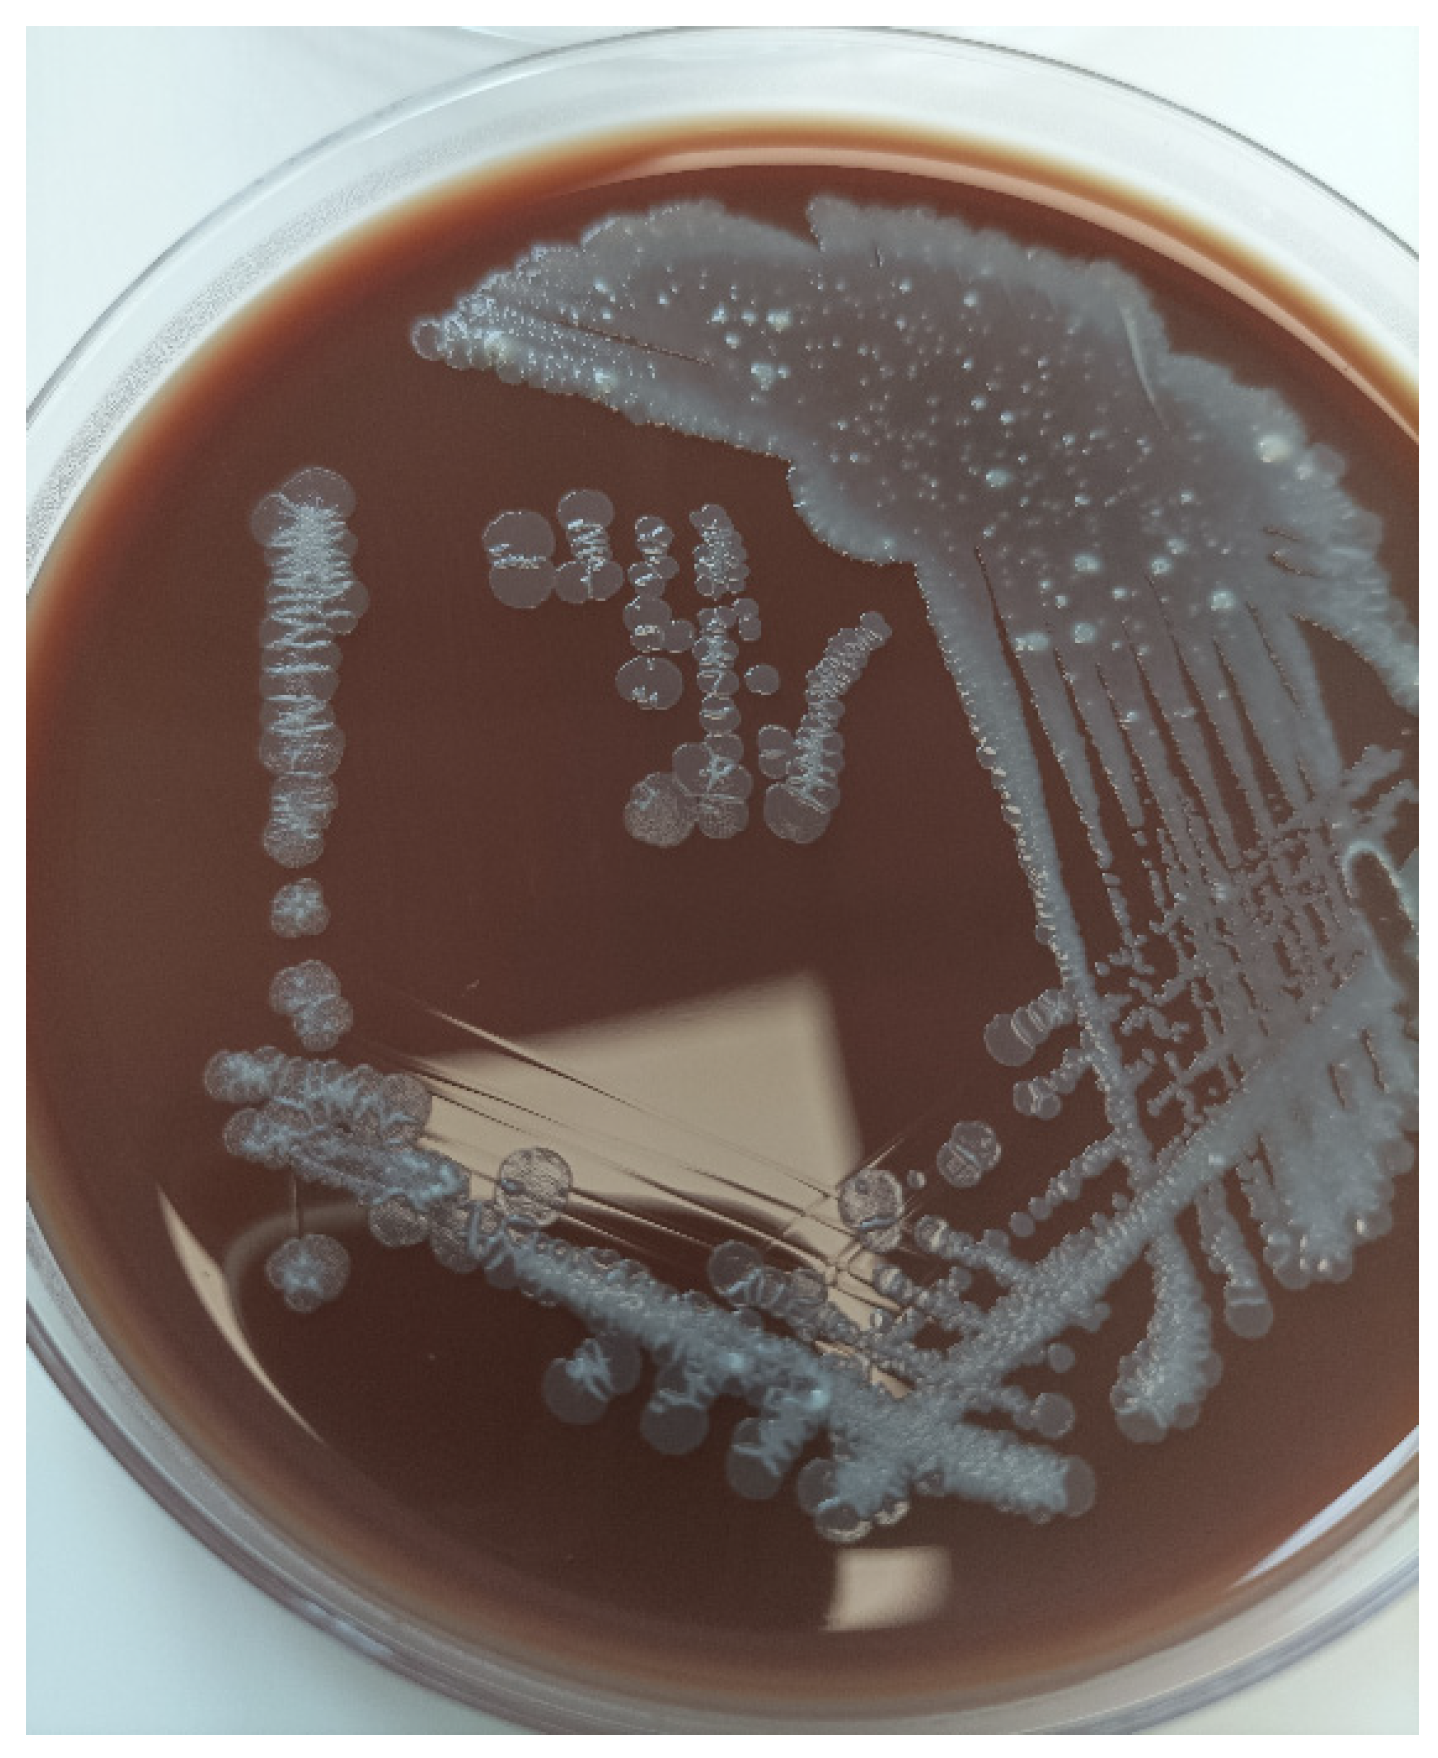
Ijms 25 04708 g002

1. Introduction
B. hinzii is a Gram-negative bacillus belonging to the genus Bordetella, which also includes other well-known species like Bordetella pertussis (causing whooping cough) and Bordetella bronchiseptica (causing respiratory infections in animals).
B. hinzii has gained attention for its association with respiratory infections in animals, especially birds and rodents. It has been found in a variety of avian species, including poultry, pigeons, and pet birds, and rodents, such as mice and rats, as it was isolated from wild rodents in Southeast Asia; these animals might serve as a reservoir [
1,
2]. In humans,
B. hinzii infections have been documented, but they are relatively rare, with just 18 cases reported in the specialty literature [
3]. Regarding respiratory infections, it is supposed that the germ colonizes the respiratory airways and then it can cause infection if the host passes through a state of immunocompromise, its activity being similar to that of an opportunistic pathogen. If treated with the correct antibiotics, the patient usually recovers from this infection [
4], but there are also cases reported to have led to death [
5,
6]. Despite its opportunistic nature, there is limited understanding of its pathogenicity, diagnostic challenges, and optimal treatment strategies, particularly in immunocompromised individuals.
The clinical range of activity of the pathogen includes pneumonia, urinary tract infection, bacteriemia, infective endocarditis, liver abscess, or soft tissue abscesses [
7,
8,
9,
10].
To the best of our knowledge, we describe the first case of acute bronchitis in an immunocompromised patient following a double-lung transplantation (DLTx) caused by B. hinzii. This case not only sheds light on the clinical implications of B. hinzii in vulnerable patient populations but also underscores the need for enhanced understanding and vigilance in managing infections caused by this emerging pathogen.
2. Case Presentation
In July 2023, a 43-year-old man, a former smoker with a history of sarcoidosis stage IV, who worked as a welder, without any exposure to poultry or other animals, underwent DLTx due to chronic respiratory failure associated with chronic obstructive pulmonary disease (COPD) stage IV, complicated with multiples infectious exacerbations, two pneumothoraxes, and bronchiectasis. Immunosuppression after transplant was maintained with an immunosuppressive regimen of tacrolimus (goal trough of 10–12 ng/mL at the time of this hospitalization), 3000 mg mycophenolic acid, and 15 mg prednisone.
One month following the DLTx surgery, the patient developed a febrile episode and inflammatory markers elevation (C-reactive protein of 45 mg/L, reference range < 5 mg/L). Empiric antibiotic therapy with intravenous cefepime 6g and oral levofloxacine 500 mg bid was initiated due to a history of multiple infectious exacerbations pre-transplantation (Achromobacter xylosoxydans, Stenotrophomonas maltophilia, Haemophilus influenzae, and multidrug resistant Escherichia coli).
The computed tomography imaging showed bronchial congestion of the left upper lobar bronchia, with bilateral parenchymal condensations more marked at the level of the middle lobe and the right basal pyramid. Also, there were some areas of ground glass opacities with septal thickening, suggesting a possible infection (
Figure 1).
A broncho-alveolar lavage was performed from the middle lobe and showed 10
7 CFU/mL
B. hinzii. B. hinzii grew on horse blood agar (bioMérieux
®, BioMérieux, Lyon, France) at 37 °C after incubation for 24 h as smooth, grey colonies (
Figure 2).
We identified
B. hinzii using matrix-assisted laser desorption/ionization time-of-flight mass spectrometry (Biotyper Bruker
®, Bruker Daltonics, Bremen, Germany). We performed antimicrobial susceptibility testing using disk diffusion and interpreted results using the 2021 European Committee on Antimicrobial Susceptibility Testing (nonspecies related) breakpoint.
B. hinzii showed resistance to amoxicillin, cefotaxime, and aminoglycosides; intermediate resistance to cefepime; and susceptibility to piperacillin/tazobactam, meropenem, imipenem, ertapenem, and trimethoprim/sulfamethoxazole. For colistin, we performed antimicrobial susceptibility testing by using Etest (bioMérieux
®), and the minimal inhibitory concentration was 2 mg/L (
Table 1).
According to the antibiogram results, we switched treatment to piperacillin/tazobactam 4.5 g tid. Subsequent to the persistence of symptoms, the patient underwent a second bronchial aspiration procedure 7 days later, which resulted in the confirmation of B hinzii infection through diagnostic testing. New antibiotic susceptibility tests were carried out, identifying acquired resistance to piperacillin/tazobactam and a susceptibility to carbapenems, trimethoprim/sulfamethoxazole, and doxycycline. In this context, the antibiotic therapy was switched to doxycycline 100 mg tid for 14 days and inhalative antibiotic treatment with colistin (2 MUI twice a day).
Based on the post operative clinical status, the patient was secondarily diagnosed with a grade I acute cellular reject and treated with a bolus of Solumedrol 1 g/day for three days. However, despite the adapted treatment for B. hinzii, the patient remained positive for the sprout, leading to a delayed treatment of the acute cellular rejection. The treatment for B. hinzii, based on oral doxycycline and nebulised colistin, was then prolonged for 14 additional days, leading to negative pulmonary samples after one month.
3. Discussion
Initially deemed harmless in birds,
B. hinzii, a Gram-negative bacillus causing respiratory illnesses in poultry, has shown potential pathogenicity in some veterinary isolates. It sporadically appears in rabbits and rodents, causing pulmonary issues in mice and bloodstream infections in rats [
2,
11,
12]. Human cases, rare and often associated with immunosuppression, SARS-CoV-2 infection, or prior poultry exposure, manifest as diverse infections, including pneumonia with or without bacteraemia. Respiratory tract infections present symptoms like cough, runny nose, congestion, and fever, with severity depending on the
Bordetella species and individual immune status [
4]. Despite our patient’s lack of exposure to poultry or birds, an increasing number of reported cases suggest a growing awareness of
B. hinzii infections, possibly due to the pathogen’s emergence, improved identification methods, and an expanding population at risk, particularly the immunosuppressed. In our case, the bacteria were resistant to amoxicillin, cefotaxime, and aminoglycosides, and intermediate-resistant to cefepime; and they acquired resistance to piperacillin/tazobactam during the treatment. Reported
B. hinzii isolates were frequently multidrug-resistant, including resistance to cephalosporins, aminoglycosides, and quinolones, but remained susceptible to piperacillin/tazobactam, carbapenems, and cyclines. The interpretation of antimicrobial susceptibility testing is not established, and the choice of antimicrobial drugs and treatment duration are not standardized.
There are case reports published in the literature regarding other
B. hinzii infection in organ transplant patients, but no other published case of
B. hinzii in a lung transplant recipient. Pechacek et al. describe an unusual case of meningitis caused by
B. hinzii in a patient with kidney transplant history. In this study, the clinical isolates of
B. hinzii displayed a susceptibility pattern to various antibiotics. They were found to be sensitive to carbapenems, piperacillin, and trimethoprim/sulfamethoxazole. However, their sensitivity to ciprofloxacin was only intermediate, suggesting that while ciprofloxacin could potentially be effective against the infection, it may not be the ideal or first-choice antibiotic due to this intermediate sensitivity [
13]. Furthermore, Arvand et al. described in his article a patient with a medical background including several liver transplantations. The patient experienced recurring episodes of cholangitis, and over a span of six months,
B. hinzii was consistently found in various samples taken from the biliary tract. While deciphering laboratory and histological results can be challenging for individuals who have undergone liver transplantation due to primary sclerosing cholangitis, it was posited that
B. hinzii played a role as the causative agent behind the prolonged biliary duct infection in this patient. Also, the bacteria resistance to β-lactam and fluoroquinolones was noted [
10].
Another study by Fabre et al. showed an infection of
B. hinzii in a bone marrow transplantation patient, and described the potential of the pathogen to spread from an avian reservoir [
4].
In our case, the patient was positive for almost one month, but there are some studies that provided evidence of the extended presence of
B. hinzii in the respiratory and gastrointestinal systems [
9,
10].
B. hinzii manifests as an opportunistic pathogen, leading to respiratory infections in individuals with cystic fibrosis [
14]. During a 12-month period, it was detected on eight separate occasions in the respiratory system of a cystic fibrosis patient [
9]. However, the infection with
B. hinzii could be one of the potential factors involved in the development of the cellular reject taking into consideration the resistance of the bacteria despite of the right treatment.
4. Conclusions
In conclusion, this is the first reported case of B. hinzii pulmonary infection in a lung transplant patient. While the exact transmission route remains unclear, the potential association with occupational exposure to B. hinzii in the respiratory tract cannot be definitively affirmed. While our findings highlight the emergence of this pathogen as a potential cause of pulmonary infections post transplantation, several important questions remain unanswered. The exact transmission route of Bordetella hinzii in immunocompromised individuals, particularly during the COVID-19 pandemic, warrants further investigation.
Moreover, the challenges encountered in diagnosing and treating B. hinzii infections underscore the importance of continued research efforts aimed at elucidating the epidemiology, pathogenesis, and optimal management approaches for this emerging pathogen. Given the rarity of reported cases and the diverse clinical manifestations associated with B. hinzii infections, collaborative multicentre studies may offer valuable insights into the prevalence, risk factors, and outcomes of such infections in different patient populations.
Furthermore, considering the potential association between occupational exposure and the presence of B. hinzii in the pulmonary tract, future studies should explore preventive measures and infection control strategies, especially in high-risk settings such as healthcare facilities and animal-related occupations. Finally, the increasing recognition of B. hinzii infections underscores the importance of vigilance among clinicians and microbiologists in identifying and managing these infections, particularly in immunocompromised individuals.
In summary, this case report underscores the need for continued research efforts to enhance our understanding of Bordetella hinzii infections and to develop evidence-based guidelines for their diagnosis, treatment, and prevention in transplant recipients and other vulnerable patient populations.
Author Contributions
Conceptualization, D.-M.V., B.P. and J.L.P.; methodology, G.D. and S.F.-S.; software, C.R. and B.P.; validation, E.F. and J.L.P.; formal analysis, D.-M.V. and L.-S.M.; investigation, D.-M.V. and A.G.; resources, E.F., D.F. and O.M.; data curation, D.-M.V. and S.F.-S.; writing—original draft preparation, D.-M.V. and B.P.; writing—review and editing, J.L.P.; visualization, J.L.P., O.L. and E.F.; supervision, J.L.P.; project administration, D.-M.V. and J.L.P.; funding acquisition, D.-M.V. All authors have read and agreed to the published version of the manuscript.
Funding
This research was funded by Ministerului Educației, prin Agenția de Credite și Burse de Studii, Romania nr 5686/25.08.2023.
Institutional Review Board Statement
This study was approved by the local ethic committee GERM (IRB number 00012157) on 15 September 2023.
Informed Consent Statement
Informed consent was obtained from the subject involved in the study.
Data Availability Statement
Data is contained within the article.
Conflicts of Interest
The authors declare no conflicts of interest.
References
- Ivanov, Y.V.; Linz, B.; Register, K.B.; Newman, J.D.; Taylor, D.L.; Boschert, K.R.; Le Guyon, S.; Wilson, E.F.; Brinkac, L.M.; Sanka, R.; et al. Identification and Taxonomic Characterization of Bordetella pseudohinzii Sp. Nov. Isolated from Laboratory-Raised Mice. Int. J. Syst. Evol. Microbiol. 2016, 66, 5452–5459. [Google Scholar] [PubMed]
- Jiyipong, T.; Morand, S.; Jittapalapong, S.; Raoult, D.; Rolain, J.M. Bordetella hinzii in Rodents, Southeast Asia. Emerg. Infect. Dis. 2013, 19, 502. [Google Scholar] [CrossRef] [PubMed]
- Maison-Fomotar, M.; Sivasubramanian, G. Bordetella hinzii Pneumonia and Bacteremia in a Patient with SARS-CoV-2 Infection. Emerg. Infect. Dis. 2021, 27, 2904. [Google Scholar] [CrossRef] [PubMed]
- Fabre, A.; Dupin, C.; Bénézit, F.; Goret, J.; Piau, C.; Jouneau, S.; Guillot, S.; Mégraud, F.; Kayal, S.; Desrues, B.; et al. Opportunistic Pulmonary Bordetella hinzii Infection after Avian Exposure. Emerg. Infect. Dis. 2015, 21, 2122. [Google Scholar] [CrossRef] [PubMed]
- Wang, Z.; Chen, G. Immune Regulation in Neurovascular Units after Traumatic Brain Injury. Neurobiol. Dis. 2023, 179, 106060. [Google Scholar] [CrossRef]
- Binkowska, A.M.; Michalak, G.; Slotwiński, R. Current Views on the Mechanisms of Immune Responses to Trauma and Infection. Cent. J. Immunol. 2015, 40, 206. [Google Scholar] [CrossRef]
- Collercandy, N.; Petillon, C.; Abid, M.; Descours, C.; Carvalho-Schneider, C.; Mereghetti, L.; Lartigue, M.F. Bordetella hinzii: An Unusual Pathogen in Human Urinary Tract Infection. J. Clin. Microbiol. 2021, 59, 2748–2768. [Google Scholar] [CrossRef]
- Negishi, T.; Matsumoto, T.; Shinagawa, J.; Kasuga, E.; Horiuchi, K.; Natori, T.; Sugano, M.; Uehara, T.; Honda, T. A Case of Cervical Subcutaneous Abscess Due to Bordetella hinzii. Diagn. Microbiol. Infect. Dis. 2019, 95, 114865. [Google Scholar] [CrossRef]
- Funke, G.; Hess, T.; Von Graevenitz, A.; Vandamme, P. Characteristics of Bordetella hinzii Strains Isolated from a Cystic Fibrosis Patient over a 3-Year Period. J. Clin. Microbiol. 1996, 34, 966. [Google Scholar] [CrossRef]
- Arvand, M.; Feldhues, R.; Mieth, M.; Kraus, T.; Vandamme, P. Chronic Cholangitis Caused by Bordetella hinzii in a Liver Transplant Recipient. J. Clin. Microbiol. 2004, 42, 2335–2337. [Google Scholar] [CrossRef] [PubMed]
- Hayashimoto, N.; Morita, H.; Yasuda, M.; Ishida, T.; Kameda, S.; Takakura, A.; Itoh, T. Prevalence of Bordetella hinzii in Mice in Experimental Facilities in Japan. Res. Vet. Sci. 2012, 93, 624–626. [Google Scholar] [CrossRef] [PubMed]
- Register, K.B.; Sacco, R.E.; Nordholm, G.E. Comparison of Ribotyping and Restriction Enzyme Analysis for Inter- and Intraspecies Discrimination of Bordetella avium and Bordetella hinzii. J. Clin. Microbiol. 2003, 41, 1512–1519. [Google Scholar] [CrossRef] [PubMed]
- Pechacek, J.; Raybould, J.; Morales, M. Bordetella hinzii Meningitis in Patient with History of Kidney Transplant, Virginia, USA. Emerg. Infect. Dis. 2021, 27, 2459. [Google Scholar] [CrossRef] [PubMed]
- Spilker, T.; Liwienski, A.A.; Lipuma, J.J. Identification of Bordetella Spp. in Respiratory Specimens from Individuals with Cystic Fibrosis. Clin. Microbiol. Infect. 2008, 14, 504–506. [Google Scholar] [CrossRef] [PubMed]
| Disclaimer/Publisher’s Note: The statements, opinions and data contained in all publications are solely those of the individual author(s) and contributor(s) and not of MDPI and/or the editor(s). MDPI and/or the editor(s) disclaim responsibility for any injury to people or property resulting from any ideas, methods, instructions or products referred to in the content. |
© 2024 by the authors. Licensee MDPI, Basel, Switzerland. This article is an open access article distributed under the terms and conditions of the Creative Commons Attribution (CC BY) license (https://creativecommons.org/licenses/by/4.0/).